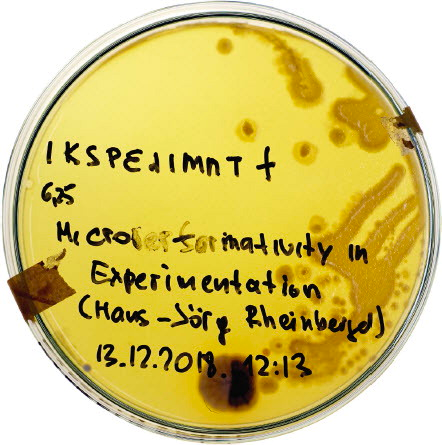
讲座预告 | 技术环宇中超越人类的展演 讲座 人类 技术 环宇 媒体 艺术 系列 线上 科技艺术学院 项目 崇真艺客

Please scroll down for English

媒体艺术21系列线上讲座
本讲座系列为科技艺术学院于2021年发起的项目“媒体艺术21:2000年以来全球媒体艺术实践与反思,及其教学探索”之组成部分。讲座依照项目目前的三个主题:“后人类”(Posthuman)、“生态”(Ecologies)、“共同体”(The Commons)分别展开。本讲座为“后人类”主题下的第一场线上讲座。
技术环宇中超越人类的展演 |
More than Human Performances in a Technospheric World
讲者:
克里斯·萨尔特(Chris Salter)
主持:
张尕(ZHANG Ga)
日期:
2021年12月14日 周二
时间:
21:00 - 22:30(北京时间)
语言:
英文(配中文现场翻译)
参与方式:
MANA线上直播(海报与文中附二维码链接)
联合主办:
中央美术学院科技艺术研究院、中央美术学院美术馆
专项支持:
和艺术基金、新媒体艺术基金会
线上直播合作:
MANA
关于讲座
一部日本戏剧作品由机器人出演(平田织佐[ Oriza Hirata ])。一位视觉艺术家在全球最大美术馆之一的中庭内,置满浮动的气球状“算法机器”,它们会制造出不同气味(安妮卡·伊[ Anicka Yi ])。一台由装满有机物(包括水果、金属、熟食等)的玻璃罐组成的复杂机器,通过塑料管及电线与矩阵相连,其实际作用是将有机物和半导体以不同组合方式进行混合,从而产生电能(让·卡通百伊·姆肯[ Jean Katambayi Mukendi ])。自千年之交以来,世界各地的画廊、美术馆、艺术节、剧场,甚至地球的天空和陆地都遭遇了一连串新型表演者的入侵,这些表演者与智人(homo sapiens)几乎毫无相似之处——它们是细菌和病毒、流体和振动、真菌和植物、计算机、刺眼的光线、机器人和机器、无人机和卫星。本次讲座试图在人类纪及对其所持异议的背景下,理解这种“后人类表演性”的转向,探讨表演艺术家、媒体艺术家和视觉艺术家是如何在不同规模与尺度上进行工作并产出作品的,这些作品不仅呈现出超越人类世界的“作为与行动”,亦在此过程中,动摇了视人类为自治及自主之实体的可能性。
关于讲者

克里斯·萨尔特(Chris Salter)是一位艺术家,蒙特利尔康考迪亚大学设计与计算艺术专业教授,蒙特利尔“六角星网络——艺术、文化与科技”(Hexagram Network for Arts, Culture and Technology)联合总监。他曾于埃默里大学和斯坦福大学学习哲学、经济学、戏剧以及计算机音乐。在与彼得·塞拉斯(Peter Sellars)、威廉·弗西斯(William Forsythe)和法兰克福芭蕾舞团(Ballett Frankfurt)合作后,他联合创立并指导了艺术与研究组织:Sponge(1997-2003年)。他的作品曾在世界各地展出,其中包括:威尼斯建筑双年展、巴比肯艺术中心、柏林艺术节、维也纳艺术节、当代艺术博物馆(Musée d’art Contemporain)、中国美术馆、巴塞罗那灯光秀(LLUM BCN 2020)、PACT Zollverein当代艺术中心、Villette Numerique艺术节、多媒体和表演艺术中心(EMPAC)、EXIT艺术节(EXIT Festival-Maison des Arts Creteil)、蒙特利尔艺术广场(Place des Arts)等等。他的著作包括:《纠缠:技术与表演的转变》(Entangled: Technology and the Transformation of Performance,麻省理工出版社,2010年)及《异体:与艺术的实验性遭遇》(Alien Agency: Experimental Encounters with Art in the Making,麻省理工出版社,2015年)。他的最新著述:《感知机器:传感器如何塑造我们的日常生活》(Sensing Machines: How Sensors Shape our Everyday Lives)将由麻省理工出版社于2022年3月出版。自2022年5月起,他将担任苏黎世艺术大学(ZHdK)沉浸式艺术专业教授以及沉浸式艺术空间总监。

《N-多胞形:希纳基斯之后的声与光行为》(N-Polytope: Behaviors in Light and Sound After Iannis Xenakis),克里斯·萨尔特及其他人,白昼之夜(Nuit-Blanche),巴黎,2015年,图片:托马斯·施皮尔(Thomas Spier)。

《徒劳无功》(Futile Labor),奥隆·凯茨(Oron Catts)、克里斯·萨尔特、德文·沃德(Devon Ward)、伊奥钠特·祖尔(Ionat Zurr),2015年,图片:德文·沃德。
从唾液样本中培养酵母细胞的培养皿,《微生物关键词》(Microbial Keywording),克劳斯·施皮斯(Klaus Spiess)、卢齐厄·施特雷克尔(Lucie Strecker),作为“应用微观表演”(Applied Microperformativity)艺术节的一部分,维也纳“应用化学创新实验室”(AIL),2018年,图片由艺术家惠允,图片版权:彼得·迈尔(Peter Mayr)。

《异体:与艺术的实验性遭遇》(Alien Agency: Experimental Encounters with Art in the Making,麻省理工出版社,2015年)
扫描下方二维码可免费参与直播:

关于项目
“媒体艺术21:2000年以来全球媒体艺术实践与反思,及其教学探索”是由中央美术学院科技艺术研究院发起的三年项目。
媒体艺术是全球当代艺术实践中不可或缺的组成部分。其以媒介的过去、现在和未来诠释世界之当下。伴随着媒体艺术实践及其在国际艺术展览中占比的日益增长,对其展开批判与学术性反思,同时将这一实践领域纳入到艺术教育的需求也在不断增加。艺术家、学者、策展人和学生能够获得原始资料并进行批判性思考,这对于研究和发展媒体艺术这样一个已经对当代艺术产生显著影响、塑造和促进作用的领域而言至关重要。“媒体艺术21——21世纪的媒体艺术”旨在以全球视野对2000年以来的媒体艺术进行概述来满足这一需求。
项目网址:http://mediaart21.org
Media Art 21 Online Lecture Series
This online lecture series is part of the Media Art 21: Practices, Reflections, and Pedagogies of Global Media Art Since 2000, a project initiated by the Institute of Sci-Tech Arts of the Central Academy of Fine Arts (CAFA) in 2021. The lectures are based on three current themes of the project: Posthuman, Ecologies, and the Commons. This is the first online lecture under the theme of the Posthuman.
More than Human Performances in a Technospheric World |
Speaker:
Chris Salter
Introduced by:
ZHANG Ga
Date:
2021.12.14 Tuesday
Time:
21:00 - 22:30 (Beijing time)
Language:
English (with Chinese translation)
Participation:
Online Streaming by MANA (QR code attached on the poster and text)
Co-organized by:
CAFA Institute of Sci-Tech Arts, CAFA Art Museum
Supported by:
HE ART FUND, New Media Arts Foundation
Online Streaming Cooperation:
MANA
About the Lecture
A theater work in Japan is performed with robots (Oriza Hirata). A visual artist fills one of the world’s largest museum atriums with floating balloon-like “algorithmic machines” that produce scents (Anicka Yi). A complex machine made up of glass jars filled with organic matter (inc. fruits, metal, cooked food etc.) is connected to matrixes via plastic tubes and electrical wires, which virtually mix organic matter with semiconductors in different combinations in order to generate electricity (Jean Katambayi Mukendi). Since the turn of the millennium and from all corners of the globe, galleries and museums, festivals, theaters and even the sky and ground of the earth has been invaded by a battery of new performers that pose little resemblance to homo sapiens: bacteria and viruses, fluids and vibrations, fungi and plants, computers, blinding lights, robots and machines, drones and satellites. This talk tries to understand this turn towards “posthuman performativity,” against the backdrop of the Anthropocene and its discontents, exploring how performing, media and visual artists working across different scales have created works that not only feature the “doings and actions” of a world beyond the human but also, in the process, undermine the possibility of thinking about the human as an autonomous and self-determined entity.
About the Speaker
Chris Salter is an artist, Professor for Design + Computation Arts at Concordia University in Montreal and Co-Director of the Hexagram Network for Arts, Culture and Technology, in Montreal. He studied philosophy, economics, theatre and computer music at Emory and Stanford Universities. After collaborating with Peter Sellars and William Forsythe/Ballett Frankfurt, he co-founded and directed the art and research organization Sponge (1997-2003). His work has been seen all over the world at such venues as the Venice Architecture Biennale, Barbican Centre, Berliner Festspiele, Wiener Festwochen, Musée d’art Contemporain, NAMOC – Beijing, LLUM BCN 2020, PACT Zollverein, Villette Numerique, EMPAC, EXIT Festival-Maison des Arts Creteil and Place des Arts, among many others. He is the author of Entangled: Technology and the Transformation of Performance (MIT Press, 2010) and Alien Agency: Experimental Encounters with Art in the Making (MIT Press 2015). His new book Sensing Machines: How Sensors Shape our Everyday Lives will be published by MIT Press in March 2022. In May 2022, he will take up the position of Professor of Immersive Arts and Director of the Immersive Arts Space at the Zurich University of the Arts (ZHdK).
About the Project
The Media Art 21: Practices, Reflections, and Pedagogies of Global Media Art Since 2000 is a three-year project initiated by the Institute of Sci-Tech Arts of the Central Academy of Fine Arts (CAFA).
Media art is an essential part of global contemporary art practice. It addresses the world of the present through the media of the past, present, and future. With the increasing artistic production of media art and its growing presence in international art exhibitions comes a growing need for critical and scholarly reflection, as well as for the inclusion of this field of practice in art education. For artists, scholars, curators, and students, access to original materials in conjunction with critical reflection is of prime importance for the study and development of an artistic field that has remarkably influenced, shaped, and stimulated contemporary art. MA21 – Media Art in the 21st century – seeks to address this need through an overview of media art since 2000 from a global perspective.
Project website: http://mediaart21.org
主编 / 何一沙
责编 / 吴靖

识别二维码,关注我们


已展示全部
更多功能等你开启...











 分享
分享